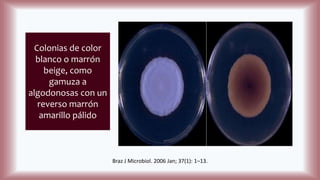
Colonias de color
blanco o marrón
beige, como
gamuza a
algodonosas con un
reverso marrón
amarillo pálido
Braz J Microbiol. 2006 Jan; 37(1): 1–13.

La histoplasmosis es una infección granulomatosa causada por el hongo dimórfico Histoplasma capsulatum, predominante en individuos inmunocomprometidos, con presentación clínica más frecuente en forma pulmonar y manifestaciones cutáneas en el 10-25% de los casos diseminados. Se distribuye mundialmente, con mayor prevalencia en América Latina y en los Estados Unidos, especialmente en áreas con humus y excrementos de aves. Las manifestaciones cutáneas incluyen pápulas, nódulos, úlceras y otras lesiones, siendo común en pacientes con VIH y otras condiciones de inmunosupresión.